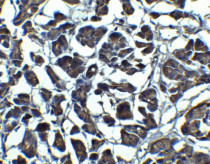

ARG59349
anti-IL23 antibody
anti-IL23 antibody for ICC/IF,IHC-Formalin-fixed paraffin-embedded sections,Western blot and Human,Mouse,Rat
概述
| 反应物种 | Hu, Ms, Rat |
|---|---|
| 应用 | ICC/IF, IHC-P, WB |
| 宿主 | Rabbit |
| 克隆 | Polyclonal |
| 同位型 | IgG |
| 靶点名称 | IL23 |
| 抗原物种 | Human |
| 抗原 | A 14 amino acid synthetic peptide within the last 50 aa of Human IL23. |
| 偶联标记 | Un-conjugated |
| 別名 | IL-23A; IL-23; IL-23 subunit alpha; IL23P19; IL-23p19; Interleukin-23 subunit alpha; IL-23-A; P19; SGRF; Interleukin-23 subunit p19 |
应用说明
| 应用建议 |
|
||||||||
|---|---|---|---|---|---|---|---|---|---|
| 应用说明 | * The dilutions indicate recommended starting dilutions and the optimal dilutions or concentrations should be determined by the scientist. | ||||||||
| 阳性对照 | Raji Cell Lysate | ||||||||
| 实际分子量 | ~ 23 kDa |
属性
| 形式 | Liquid |
|---|---|
| 纯化 | Affinity purification with immunogen. |
| 缓冲液 | PBS and 0.02% Sodium azide |
| 抗菌剂 | 0.02% Sodium azide |
| 浓度 | 1 mg/ml |
| 存放说明 | For continuous use, store undiluted antibody at 2-8°C for up to a week. For long-term storage, aliquot and store at -20°C or below. Storage in frost free freezers is not recommended. Avoid repeated freeze/thaw cycles. Suggest spin the vial prior to opening. The antibody solution should be gently mixed before use. |
| 注意事项 | For laboratory research only, not for drug, diagnostic or other use. |
生物信息
| 数据库连接 | |
|---|---|
| 基因名称 | IL23A |
| 全名 | interleukin 23, alpha subunit p19 |
| 背景介绍 | This gene encodes a subunit of the heterodimeric cytokine interleukin 23 (IL23). IL23 is composed of this protein and the p40 subunit of interleukin 12 (IL12B). The receptor of IL23 is formed by the beta 1 subunit of IL12 (IL12RB1) and an IL23 specific subunit, IL23R. Both IL23 and IL12 can activate the transcription activator STAT4, and stimulate the production of interferon-gamma (IFNG). In contrast to IL12, which acts mainly on naive CD4(+) T cells, IL23 preferentially acts on memory CD4(+) T cells. [provided by RefSeq, Jul 2008] |
| 生物功能 | Associates with IL12B to form the IL-23 interleukin, a heterodimeric cytokine which functions in innate and adaptive immunity. IL-23 may constitute with IL-17 an acute response to infection in peripheral tissues. IL-23 binds to a heterodimeric receptor complex composed of IL12RB1 and IL23R, activates the Jak-Stat signaling cascade, stimulates memory rather than naive T-cells and promotes production of proinflammatory cytokines. IL-23 induces autoimmune inflammation and thus may be responsible for autoimmune inflammatory diseases and may be important for tumorigenesis. [UniProt] |
| 细胞定位 | Secreted. Note=Secreted upon association with IL12B. [UniProt] |
| 预测分子量 | 21 kDa |
检测图片 (5) Click the Picture to Zoom In
-
ARG59349 anti-IL23 antibody IF image
Immunofluorescence: Raji cells stained with ARG59349 anti-IL23 antibody at 20 µg/ml dilution.
-
ARG59349 anti-IL23 antibody IHC-P image
Immunohistochemistry: Paraffin-embedded Human pancreas stained with ARG59349 anti-IL23 antibody (red) at 20 µg/ml dilution. Blue: DAPI staining.
-
ARG59349 anti-IL23 antibody WB image
Western blot: Raji cell lysate stained with ARG59349 anti-IL23 antibody at 1 µg/ml in the absence and presence of blocking peptide.
-
ARG59349 anti-IL23 antibody ICC image
Immunocytochemistry: Raji cells stained with ARG59349 anti-IL23 antibody at 10 µg/ml dilution.
-
ARG59349 anti-IL23 antibody IHC-P image
Immunohistochemistry: Paraffin-embedded Human pancreas stained with ARG59349 anti-IL23 antibody at 5 µg/ml dilution.